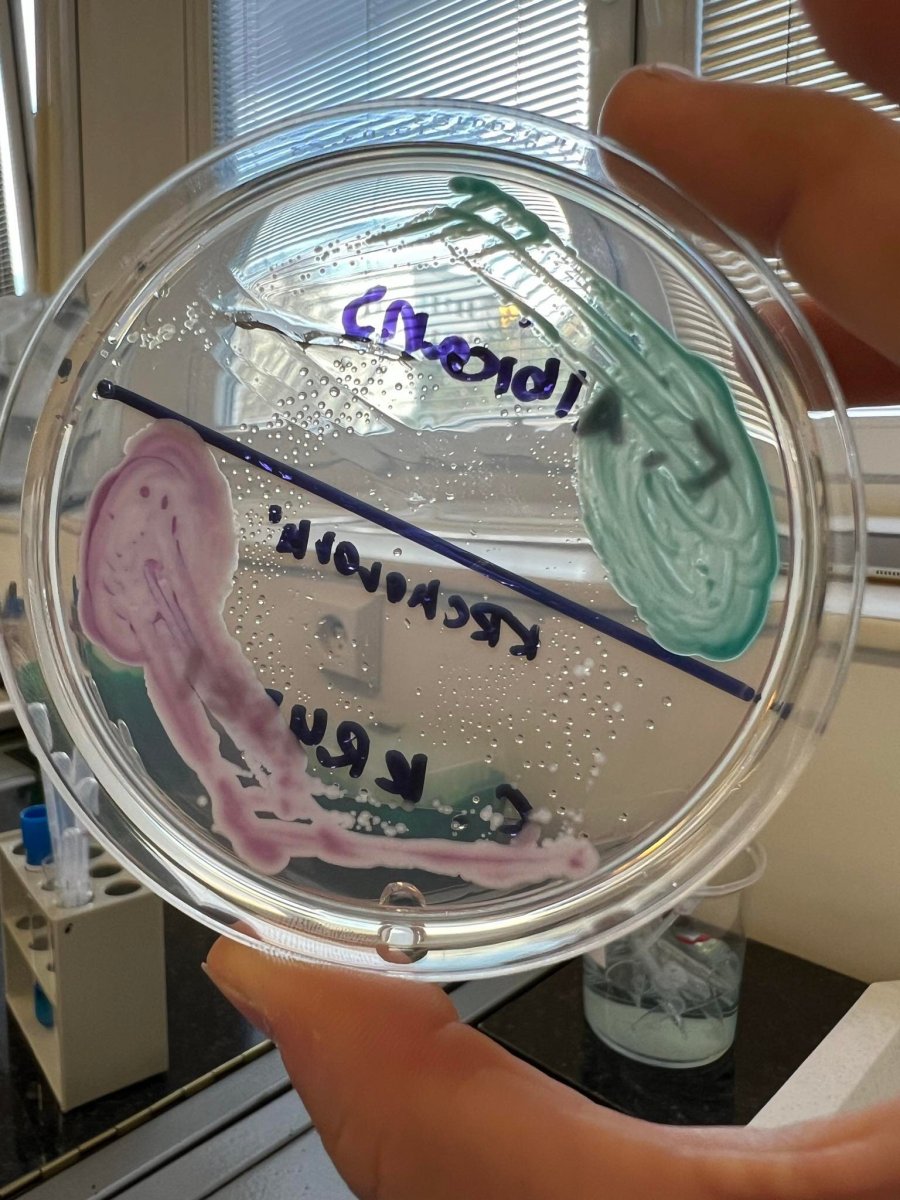

Jaký je druhák na medicíně v Hradci Králové?
Datum publikace: 13.04.2023
Aneb zasloužená odměna po prváku
Ahoj, dlouho tady nebyl žádný článek a myslím že je čas k tomu nějaký myšlenky hodit zase sem na web. Dnes vám popíšu jak vnímám druhý ročník na všeobecném lékařství v Hradci Králové.
Oproti prváku velká změna, mega moc, teda alespoň za mě. Do druháku vstupuje většina studentů již s tím že vědí jak se mají učit, co je pro ně efektivní a orientace na škole a v celém systému je lepší. Máte víc klid na duši a více času na tu životní rovnováhu.
PŘEDMĚTY
V zimním semestru máte tyto předměty.
Biologie - biologie je dvousemestrální a započali jste ji již v letním semestru v prváku a tak vám navazuje na zimní semestr ve druháku kde následně děláte v zimním zkouškovém zápočet a zkoušku.
Fyziologie - fyziologie je opět dvousemestrální, máte ji celý druhák, v letním zkouškovém zakončujete zkouškou.
Biochemie - dvousemestrální, v letním zkouškovém zakončujete zkouškou. V zimním semestru vás čeká obecná chemie ze střední kde jdete více do hloubky, pro z vás kdo nemáte problém s chemií bude to brnkačka. My kteří s chemií problém trošku máme se hold trošku zapotíme. V letním semestru v momentální chvíli jedeme metabolismy úplně všeho možného co metabolismus má.
Základy psychosomatické medicíny a komunikace s pacientem - jednosemestrální, zakončen písemnou zkouškou. Za mě super předmět. Probíráte například jak jednat s problémovými pacienty, vztah s pacientem. Jedná se o předmět kde můžete rozvíjet svoji empatii.
Základy péče o pacienta - tento předmět je dvousemestrální, opět máte ho celý druhák. V tomto předmětu rozebíráte určité nemocniční úkony, například jak převazovat určitý typ rány, druhy injekcí, jak zavést katetr a tak. Na naší fakultě si v tomto předmětu i vše vyzkoušíte na figurínách.
Jako volitelné předměty na zimní semestr jsem měla dějiny lékařství a tělák.
Letní semestr
V letním semestru vám přibyde mikrobiologie, první pomoc a plus se vám započítává letní prázdninová praxe kde budete 14 dní v nemocnici a týden v sociálním zařízení které si vyberete.
Jako hlavní předměty na které se musíte zaměřit je v zimním semestru určitě biologie. A po celý rok biochemie a fyziologie jako hlavní předměty kde je opravdu důležitá příprava a umět si věci dobře propojovat. Upřímně už teď mám z těchto zkoušek velký respekt.
Ikdyž každý týden z něčeho píšeme, ať už je to fyziologie nebo biochemie, oproti prváku je to vše doopravdy klidnější a nejste tak moc pod tlakem jak se mi zdálo minulý rok.
Zvládam více věcí a může se více odreagovat, jezdit za rodinou a dokonce si stíhám i pravidelně vařit. Takže ať žije druhák.
Dělat, co máš rád, znamená být svobodný.
Proč se učit z videí?
Člověk se více soustředí, využívá aktivně vizuální paměť a ta je při jakémkoliv zapamatování hodně důležitá. Nejenže si zapamatuje víc věcí, ale dané věci si dokážete vizuálně lépe vybavit, než kdybyste četli text z pouze knížky.

Stručný obsah
Informace podávám stručně, postupuji od jednoduššího ke složitějšímu.

Materiály ke stažení
Ke každému videu najdeš zpracovaná skripta z videí ze kterých se můžeš učit.

Ověřené zdroje
Fakta a informace použitá ve videu jsou z knih ze kterých se učíte i určitě i Vy.